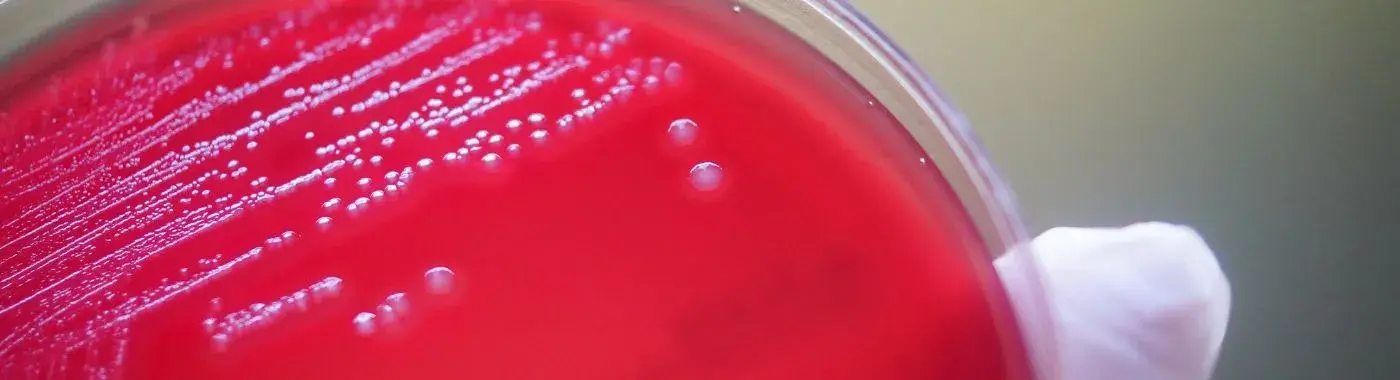
Clostridium Perfringens - Causes, Symptoms, Diagnosis, Treatment, and Prevention

- Diseases and Conditions
- Clostridium Perfringens - Causes, Symptoms, Diagnosis, Treatment, and Prevention
Clostridium Perfringens - Causes, Symptoms, Diagnosis, Treatment, and Prevention
Clostridium Perfringens: Understanding the Bacterium and Its Impact on Health
Introduction
Clostridium perfringens is a type of bacteria that plays a significant role in both foodborne illnesses and serious medical conditions. This bacterium is known for its ability to produce toxins that can lead to various health issues, ranging from mild gastrointestinal disturbances to life-threatening infections. Understanding Clostridium perfringens is crucial for both prevention and treatment, as it can have serious implications for public health.
Definition
What is Clostridium Perfringens?
Clostridium perfringens is a gram-positive, anaerobic bacterium that is commonly found in the environment, particularly in soil, water, and the intestines of humans and animals. It is one of the most prevalent causes of food poisoning worldwide and is also associated with a range of other medical conditions, including gas gangrene and necrotizing enteritis. The bacterium is known for its rapid growth and ability to produce various toxins, which can lead to severe health complications.
Causes and Risk Factors
Infectious/Environmental Causes
Clostridium perfringens is primarily transmitted through contaminated food, particularly undercooked meats, poultry, and gravies. The bacterium thrives in environments where food is kept warm for extended periods, allowing it to multiply rapidly. In addition to foodborne transmission, C. perfringens can also be found in soil and can enter the body through wounds, leading to infections.
Genetic/Autoimmune Causes
While there are no specific genetic or autoimmune causes associated with Clostridium perfringens infections, individuals with weakened immune systems or underlying health conditions may be more susceptible to severe outcomes. Genetic predispositions to certain conditions may also influence how the body responds to infections.
Lifestyle and Dietary Factors
Dietary habits play a significant role in the risk of Clostridium perfringens infections. Consuming improperly stored or undercooked foods increases the likelihood of exposure. Additionally, lifestyle factors such as poor hygiene practices, particularly in food preparation, can contribute to the spread of this bacterium.
Key Risk Factors
- Age: Young children and the elderly are at higher risk due to weaker immune systems.
- Gender: Males may be more susceptible to certain infections due to lifestyle factors.
- Geographic Location: Areas with poor sanitation and food safety practices may have higher rates of infection.
- Underlying Conditions: Individuals with diabetes, cancer, or other chronic illnesses may be more vulnerable to severe infections.
Symptoms
Common Symptoms of Clostridium Perfringens
The symptoms of Clostridium perfringens infections can vary depending on the type of illness. Common symptoms include:
- Gastroenteritis: Symptoms may include abdominal cramps, diarrhea, nausea, and vomiting, typically occurring within 6 to 24 hours after consuming contaminated food.
- Gas Gangrene: This severe condition is characterized by sudden pain, swelling, and discoloration of the skin, along with fever and a foul-smelling discharge from the wound.
- Necrotizing Enteritis: Symptoms may include severe abdominal pain, vomiting, and diarrhea, which can lead to dehydration and shock.
Warning Signs for Immediate Medical Attention
Certain symptoms warrant immediate medical attention, including:
- Severe abdominal pain that does not improve
- High fever (above 101°F or 38.3°C)
- Signs of dehydration (dry mouth, decreased urination, dizziness)
- Rapid heart rate or confusion
- Swelling and severe pain in a wound area
Diagnosis
Clinical Evaluation
The diagnosis of Clostridium perfringens infections begins with a thorough clinical evaluation. Healthcare providers will take a detailed patient history, including recent food consumption and any underlying health conditions. A physical examination will focus on symptoms and any visible signs of infection.
Diagnostic Tests
- Laboratory Tests: Stool samples may be tested for the presence of C. perfringens or its toxins. Blood tests can also help identify infections.
- Imaging Studies: In cases of gas gangrene or necrotizing enteritis, imaging studies such as X-rays or CT scans may be used to assess the extent of tissue damage.
- Specialized Procedures: In severe cases, surgical intervention may be necessary to remove infected tissue.
Differential Diagnosis
Healthcare providers will consider other conditions that may present with similar symptoms, such as:
- Other types of food poisoning (e.g., Salmonella, E. coli)
- Appendicitis
- Pancreatitis
- Diverticulitis
Treatment Options
Medical Treatments
- Antibiotics: The primary treatment for Clostridium perfringens infections often includes antibiotics such as penicillin or clindamycin, especially in cases of gas gangrene.
- Surgical Intervention: In severe cases, surgical removal of infected tissue may be necessary to prevent the spread of infection.
- Supportive Care: Patients may require intravenous fluids to manage dehydration and electrolyte imbalances.
Non-Pharmacological Treatments
- Dietary Changes: For mild gastrointestinal symptoms, a bland diet may help alleviate discomfort.
- Hydration: Maintaining hydration is crucial, especially in cases of diarrhea and vomiting.
- Alternative Therapies: Some patients may benefit from probiotics, although more research is needed in this area.
Special Considerations for Different Populations
- Pediatric Patients: Young children may require careful monitoring for dehydration and may need adjusted dosages of medications.
- Geriatric Patients: Older adults may have different responses to infections and treatments, necessitating a tailored approach.
Complications
Potential Complications
If left untreated or poorly managed, Clostridium perfringens infections can lead to serious complications, including:
- Sepsis: A life-threatening response to infection that can lead to organ failure.
- Tissue Necrosis: In cases of gas gangrene, rapid tissue death can occur, necessitating extensive surgical intervention.
- Long-term Gastrointestinal Issues: Some individuals may experience ongoing digestive problems following an infection.
Short-term and Long-term Complications
Short-term complications may include severe dehydration and electrolyte imbalances, while long-term complications can involve chronic pain or digestive issues, particularly in cases of necrotizing enteritis.
Prevention
Strategies for Prevention
Preventing Clostridium perfringens infections involves several key strategies:
- Food Safety: Proper cooking and storage of food are essential. Foods should be kept at safe temperatures, and leftovers should be refrigerated promptly.
- Hygiene Practices: Regular handwashing, especially before food preparation, can reduce the risk of contamination.
- Education: Public awareness campaigns can help inform individuals about safe food handling practices.
Recommendations
- Vaccinations: While there is no specific vaccine for C. perfringens, staying up-to-date on general vaccinations can help protect against other infections.
- Dietary Modifications: A balanced diet that includes safe food handling practices can reduce the risk of foodborne illnesses.
Prognosis & Long-Term Outlook
Typical Course of the Disease
The prognosis for Clostridium perfringens infections varies depending on the severity of the illness and the timeliness of treatment. Most individuals with mild gastroenteritis recover fully within a few days, while those with more severe infections may require longer recovery times and more intensive treatment.
Factors Influencing Prognosis
Early diagnosis and treatment adherence are critical factors that influence the overall prognosis. Individuals with underlying health conditions may face a more complicated recovery process.
Frequently Asked Questions (FAQs)
- What are the common symptoms of Clostridium perfringens infection? Common symptoms include abdominal cramps, diarrhea, nausea, and vomiting. In severe cases, symptoms may escalate to high fever and severe abdominal pain.
- How is Clostridium perfringens transmitted? The bacterium is primarily transmitted through contaminated food, particularly undercooked meats and poultry. It can also enter the body through wounds.
- What should I do if I suspect I have a Clostridium perfringens infection? If you experience severe symptoms, such as high fever or severe abdominal pain, seek medical attention immediately. For mild symptoms, stay hydrated and consult a healthcare provider if symptoms persist.
- Can Clostridium perfringens infections be treated? Yes, infections can be treated with antibiotics and, in severe cases, surgical intervention may be necessary.
- How can I prevent Clostridium perfringens infections? Preventive measures include practicing good food safety, proper cooking and storage of food, and maintaining good hygiene practices.
- Are there any long-term effects of Clostridium perfringens infections? Some individuals may experience ongoing digestive issues or chronic pain, particularly after severe infections.
- Is Clostridium perfringens dangerous? While many infections are mild, C. perfringens can cause severe and potentially life-threatening conditions, such as gas gangrene.
- What is the recovery time for Clostridium perfringens infections? Recovery time varies; mild cases may resolve within a few days, while severe cases may take longer and require more intensive treatment.
- Can I get Clostridium perfringens from eating leftovers? Yes, if leftovers are not stored properly or reheated to safe temperatures, they can harbor C. perfringens.
- When should I see a doctor for Clostridium perfringens symptoms? Seek medical attention if you experience severe symptoms, such as high fever, severe abdominal pain, or signs of dehydration.
When to See a Doctor
Immediate medical attention should be sought if you experience:
- Severe abdominal pain that does not improve
- High fever (above 101°F or 38.3°C)
- Signs of dehydration (dry mouth, decreased urination, dizziness)
- Rapid heart rate or confusion
- Swelling and severe pain in a wound area
Conclusion & Disclaimer
Clostridium perfringens is a significant bacterium that can lead to various health issues, from mild food poisoning to severe infections. Understanding its causes, symptoms, and treatment options is essential for effective management and prevention. Always consult a healthcare professional for personalized medical advice and treatment.
Disclaimer: This article is for informational purposes only and does not replace professional medical advice. Always consult a healthcare provider for medical concerns or questions.


 Best Hospital Near me Chennai
Best Hospital Near me Chennai

